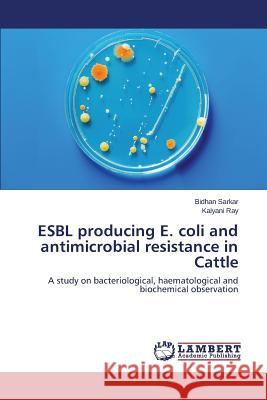
ESBL producing E. coli and antimicrobial resistance in Cattle Sarkar Bidhan 9783659795046

Wyniki wyszukiwania:
wyszukanych pozycji: 45
 |
Breeding Biotechnology and Seed Production of Field Crops
ISBN: 9789381450680 / Angielski / Twarda / 2013 / 640 str. Termin realizacji zamówienia: ok. 30 dni roboczych. In modern days, crop improvement is a multidisciplinary division of agriculture. In this book, entitled, "Breeding, Biotechnology and Seed Production of Field Crops", emphasis has been given on principles, methods and practices in plant breeding, biotechnology in crop improvement and seed production of field crops. The book has been written for all sections of learners, educators and staff-members of seed industries. Particular importance has been underlined for postgraduate students who specialize in plant breeding and seed science. Each of the book has been designed as per the recommended...
In modern days, crop improvement is a multidisciplinary division of agriculture. In this book, entitled, "Breeding, Biotechnology and Seed Production ...
|
cena:
890,57 |
 |
Study of Sediment Erosion in Francis Turbine Runner
ISBN: 9783659381652 / Angielski / Miękka / 2013 / 144 str. Termin realizacji zamówienia: ok. 10-14 dni roboczych. Sediment erosion in hydraulic turbines has been a major challenge in development of hydropower projects in Nepal. The rivers in this region carry large amount of sediments containing hard abrasive minerals, which cause rapid erosion of turbine components and affect the performance of turbines. This in turn decreases the efficiency, reliability and operating life of the projects. Recent studies have shown that it is possible to reduce such effects in Francis turbines through optimization in the hydraulic design of turbine runner. This book explains about comparative study of sediment erosion...
Sediment erosion in hydraulic turbines has been a major challenge in development of hydropower projects in Nepal. The rivers in this region carry larg...
|
cena:
279,48 |
 |
Biodiversity of Local Land Races of Rice (Oryza sativa L.)
ISBN: 9786202057608 / Angielski / Miękka / 2017 / 248 str. Termin realizacji zamówienia: ok. 10-14 dni roboczych. |
cena:
315,60 |
 |
Biodiversit? delle razze terrestri locali di riso (Oryza sativa L.)
ISBN: 9786207796472 / Włoski Termin realizacji zamówienia: ok. 10-14 dni roboczych. |
cena:
315,60 |
 |
Abiotic Stress Tolerance in Crop Plants
ISBN: 9788196053680 / Angielski Termin realizacji zamówienia: ok. 30 dni roboczych. |
cena:
343,73 |
 |
Biodiversidade das ra?as terrestres locais de arroz (Oryza sativa L.)
ISBN: 9786207796465 / Portugalski Termin realizacji zamówienia: ok. 10-14 dni roboczych. |
cena:
315,60 |
 |
Arificial Seeds Technology: An Emerging Avenue of Seed Science and Applied Biotechnology
ISBN: 9789387973596 / Angielski / Twarda / 2019 / 246 str. Termin realizacji zamówienia: ok. 30 dni roboczych. |
cena:
1109,30 |
 |
Biodiversit?t lokaler Landrassen von Reis (Oryza sativa L.)
ISBN: 9786207796519 / Niemiecki Termin realizacji zamówienia: ok. 10-14 dni roboczych. |
cena:
315,60 |
 |
Biodiversit? des races locales de riz (Oryza sativa L.)
ISBN: 9786207796496 / Francuski Termin realizacji zamówienia: ok. 10-14 dni roboczych. |
cena:
315,60 |
 |
Artificial Seeds Technology: An Emerging Avenue of Seed Science and Applied Biotechnology
ISBN: 9780367633561 / Angielski / Twarda / 2020 / 220 str. Termin realizacji zamówienia: ok. 16-18 dni roboczych. |
cena:
593,71 |
 |
Arificial Seeds Technology: An Emerging Avenue of Seed Science and Applied Biotechnology
ISBN: 9788119002740 / Angielski Termin realizacji zamówienia: ok. 30 dni roboczych. |
cena:
447,89 |
 |
SYNTHETIC SEED : A Challenging Technology in Plant Propagation, Transportation and Conservation
ISBN: 9783838333427 / Angielski / Miękka / 2010 / 240 str. Termin realizacji zamówienia: ok. 10-14 dni roboczych. |
cena:
356,69 |
 |
Radical Doubt: Turning Uncertainty Into Surefire Success
ISBN: 9781635769340 / Angielski / Twarda / 2025 / 320 str. Termin realizacji zamówienia: ok. 16-18 dni roboczych. |
cena:
118,13 |
|
ESBL producing E. coli and antimicrobial resistance in Cattle
ISBN: 9783659795046 / Angielski / Miękka / 2015 / 68 str. Termin realizacji zamówienia: ok. 10-14 dni roboczych. E. coli are commonly found in the intestinal tract of humans and other animal species and constitute a reservoir of resistant genes for potentially pathogenic bacteria. E. coli are one of the important bacterial pathogens responsible for uterine infections in cow. Extended-spectrum beta-lactamases (ESBLs) are a novel group of enzyme, was detected in the mid-1980s among Serratiamarcescens and Klebsiellapneumoniae in Germany which produced by bacteria belongs to Enterobacteriaceae family and confer resistance to an extended-spectrum of cephalosporins besides penicillins and monobactams. From...
E. coli are commonly found in the intestinal tract of humans and other animal species and constitute a reservoir of resistant genes for potentially pa...
|
cena:
180,15 |
 |
Breeding, Biotechnology and Seed Production of Field Crops
ISBN: 9788119072347 / Angielski Termin realizacji zamówienia: ok. 30 dni roboczych. |
cena:
447,89 |
 |
River Health and Ecology in South Asia: Pollution, Restoration, and Conservation
ISBN: 9783030835521 / Angielski / Twarda / 2021 / 352 str. Termin realizacji zamówienia: ok. 16-18 dni roboczych. |
cena:
406,31 |
 |
Toughening of Epoxy Networks by Some New Synthesized Toughening Agents
ISBN: 9783639711479 / Angielski / Miękka / 2014 / 100 str. Termin realizacji zamówienia: ok. 10-14 dni roboczych. With the development of polymer science and technology, people started using polymer as a material in various applications, both where other material cannot be used and as replacements for the conventional materials e.g. metals, ceramics, wood etc. Plastics are the class of polymers, characterized by high strength and load bearing capacity. Hence they are widely used in structural engineering applications.However, the poor fracture resistance of many commercial plastics restricts their use for such applications.Unlike the modification of thermoplastics, which often requires only the simple...
With the development of polymer science and technology, people started using polymer as a material in various applications, both where other material ...
|
cena:
270,45 |
 |
Medicinal and Aromatic Plants Utilization and Conservation Techniques
ISBN: 9789390083046 / Angielski / Twarda / 2020 / 450 str. Termin realizacji zamówienia: ok. 30 dni roboczych. |
cena:
927,02 |
Carbon: The Next Silicon?: Book 2--Applications
ISBN: 9781606508831 / Angielski / Miękka / 2016 / 222 str. Termin realizacji zamówienia: ok. 16-18 dni roboczych. Nuclear Magnetic Resonance (NMR) and Electron Spin Resonance (ESR) spectroscopies are well-known characterization techniques that reveal the molecular details of a sample non-invasively. The authors discuss how NMR can provide useful information on the microstructure of carbon and its surface properties and explain how C-MEMS/C-NEMS technology can be explored for building improved NMR microdevices. The authors highlight the manipulation of fluids and particles by dielectrophoresis and the use of carbon electrodes for dielectrophoresis in Lab-on-a-Chip. The use of these electrodes in... Nuclear Magnetic Resonance (NMR) and Electron Spin Resonance (ESR) spectroscopies are well-known characterization techniques that reveal the molecu... |
|
cena:
314,80 |
 |
Medicinal and Aromatic Plants: Utilization and Conservation
ISBN: 9789389571875 / Angielski / Twarda / 2019 / 450 str. Termin realizacji zamówienia: ok. 30 dni roboczych. |
cena:
1171,80 |











